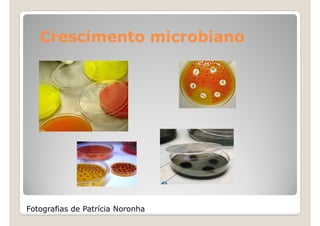
Crescimento microbiano




Fotografias de Patrícia Noronha

Este documento discute a microbiologia e os micróbios. Apresenta os primeiros cientistas a estudar micróbios como Hipócrates e Leonardo da Vinci. Também discute cientistas como Darwin, Pasteur e seus estudos de micróbios e teorias da evolução. Explica diferentes tipos de micróbios como bactérias, fungos, vírus e protozoários e como alguns são benéficos para a produção de alimentos enquanto outros podem causar doenças.